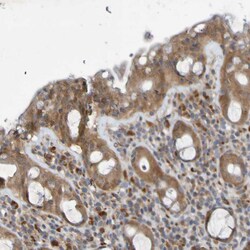

Promotional price valid on web orders only. Your contract pricing may differ. Interested in signing up for a dedicated account number?
Learn More
Learn More
Invitrogen™ SDK1 Polyclonal Antibody


Rabbit Polyclonal Antibody
Supplier: Invitrogen™ PA552827
Description
Immunogen sequence: ICNKYNGAVL TESVSLKEKS ADASESEATD SDYEDALPKH SFVNHYMSDP TYYNSWKRRA QGRAPAPHRY EAVAGSEAGA QLHPVITTQS AGGVYTPAGP GARTPLTGFS S Highest antigen sequence identity to the following orthologs: Mouse - 86%, Rat - 35%.
The protein encoded by this gene is a member of the immunoglobulin superfamily. The protein contains six immunoglobulin-like domains and thirteen fibronectin type III domains. Fibronectin type III domains are present in both extracellular and intracellular proteins and tandem repeats are known to contain binding sites for DNA, heparin and the cell surface. Alternative splicing results in multiple transcript variants.
Specifications
| SDK1 | |
| Polyclonal | |
| Unconjugated | |
| SDK1 | |
| 5330440E10; 6720466O15Rik; Protein sidekick-1; RGD1560686; Sdk1; sidekick cell adhesion molecule 1; sidekick homolog 1; sidekick homolog 1 (chicken); sidekick homolog 1, cell adhesion molecule | |
| Rabbit | |
| Antigen Affinity Chromatography | |
| RUO | |
| 221935 | |
| Store at 4°C short term. For long term storage, store at -20°C, avoiding freeze/thaw cycles. | |
| Liquid |
| Immunohistochemistry (Paraffin), Immunocytochemistry | |
| 0.1 mg/mL | |
| PBS with 40% glycerol and 0.02% sodium azide; pH 7.2 | |
| Q7Z5N4 | |
| SDK1 | |
| Recombinant protein corresponding to Human SDK1. Recombinant protein control fragment (Product #RP-90320). | |
| 100 μL | |
| Primary | |
| Human | |
| Antibody | |
| IgG |
Product Content Correction
Your input is important to us. Please complete this form to provide feedback related to the content on this product.
Product Title
Spot an opportunity for improvement?Share a Content Correction